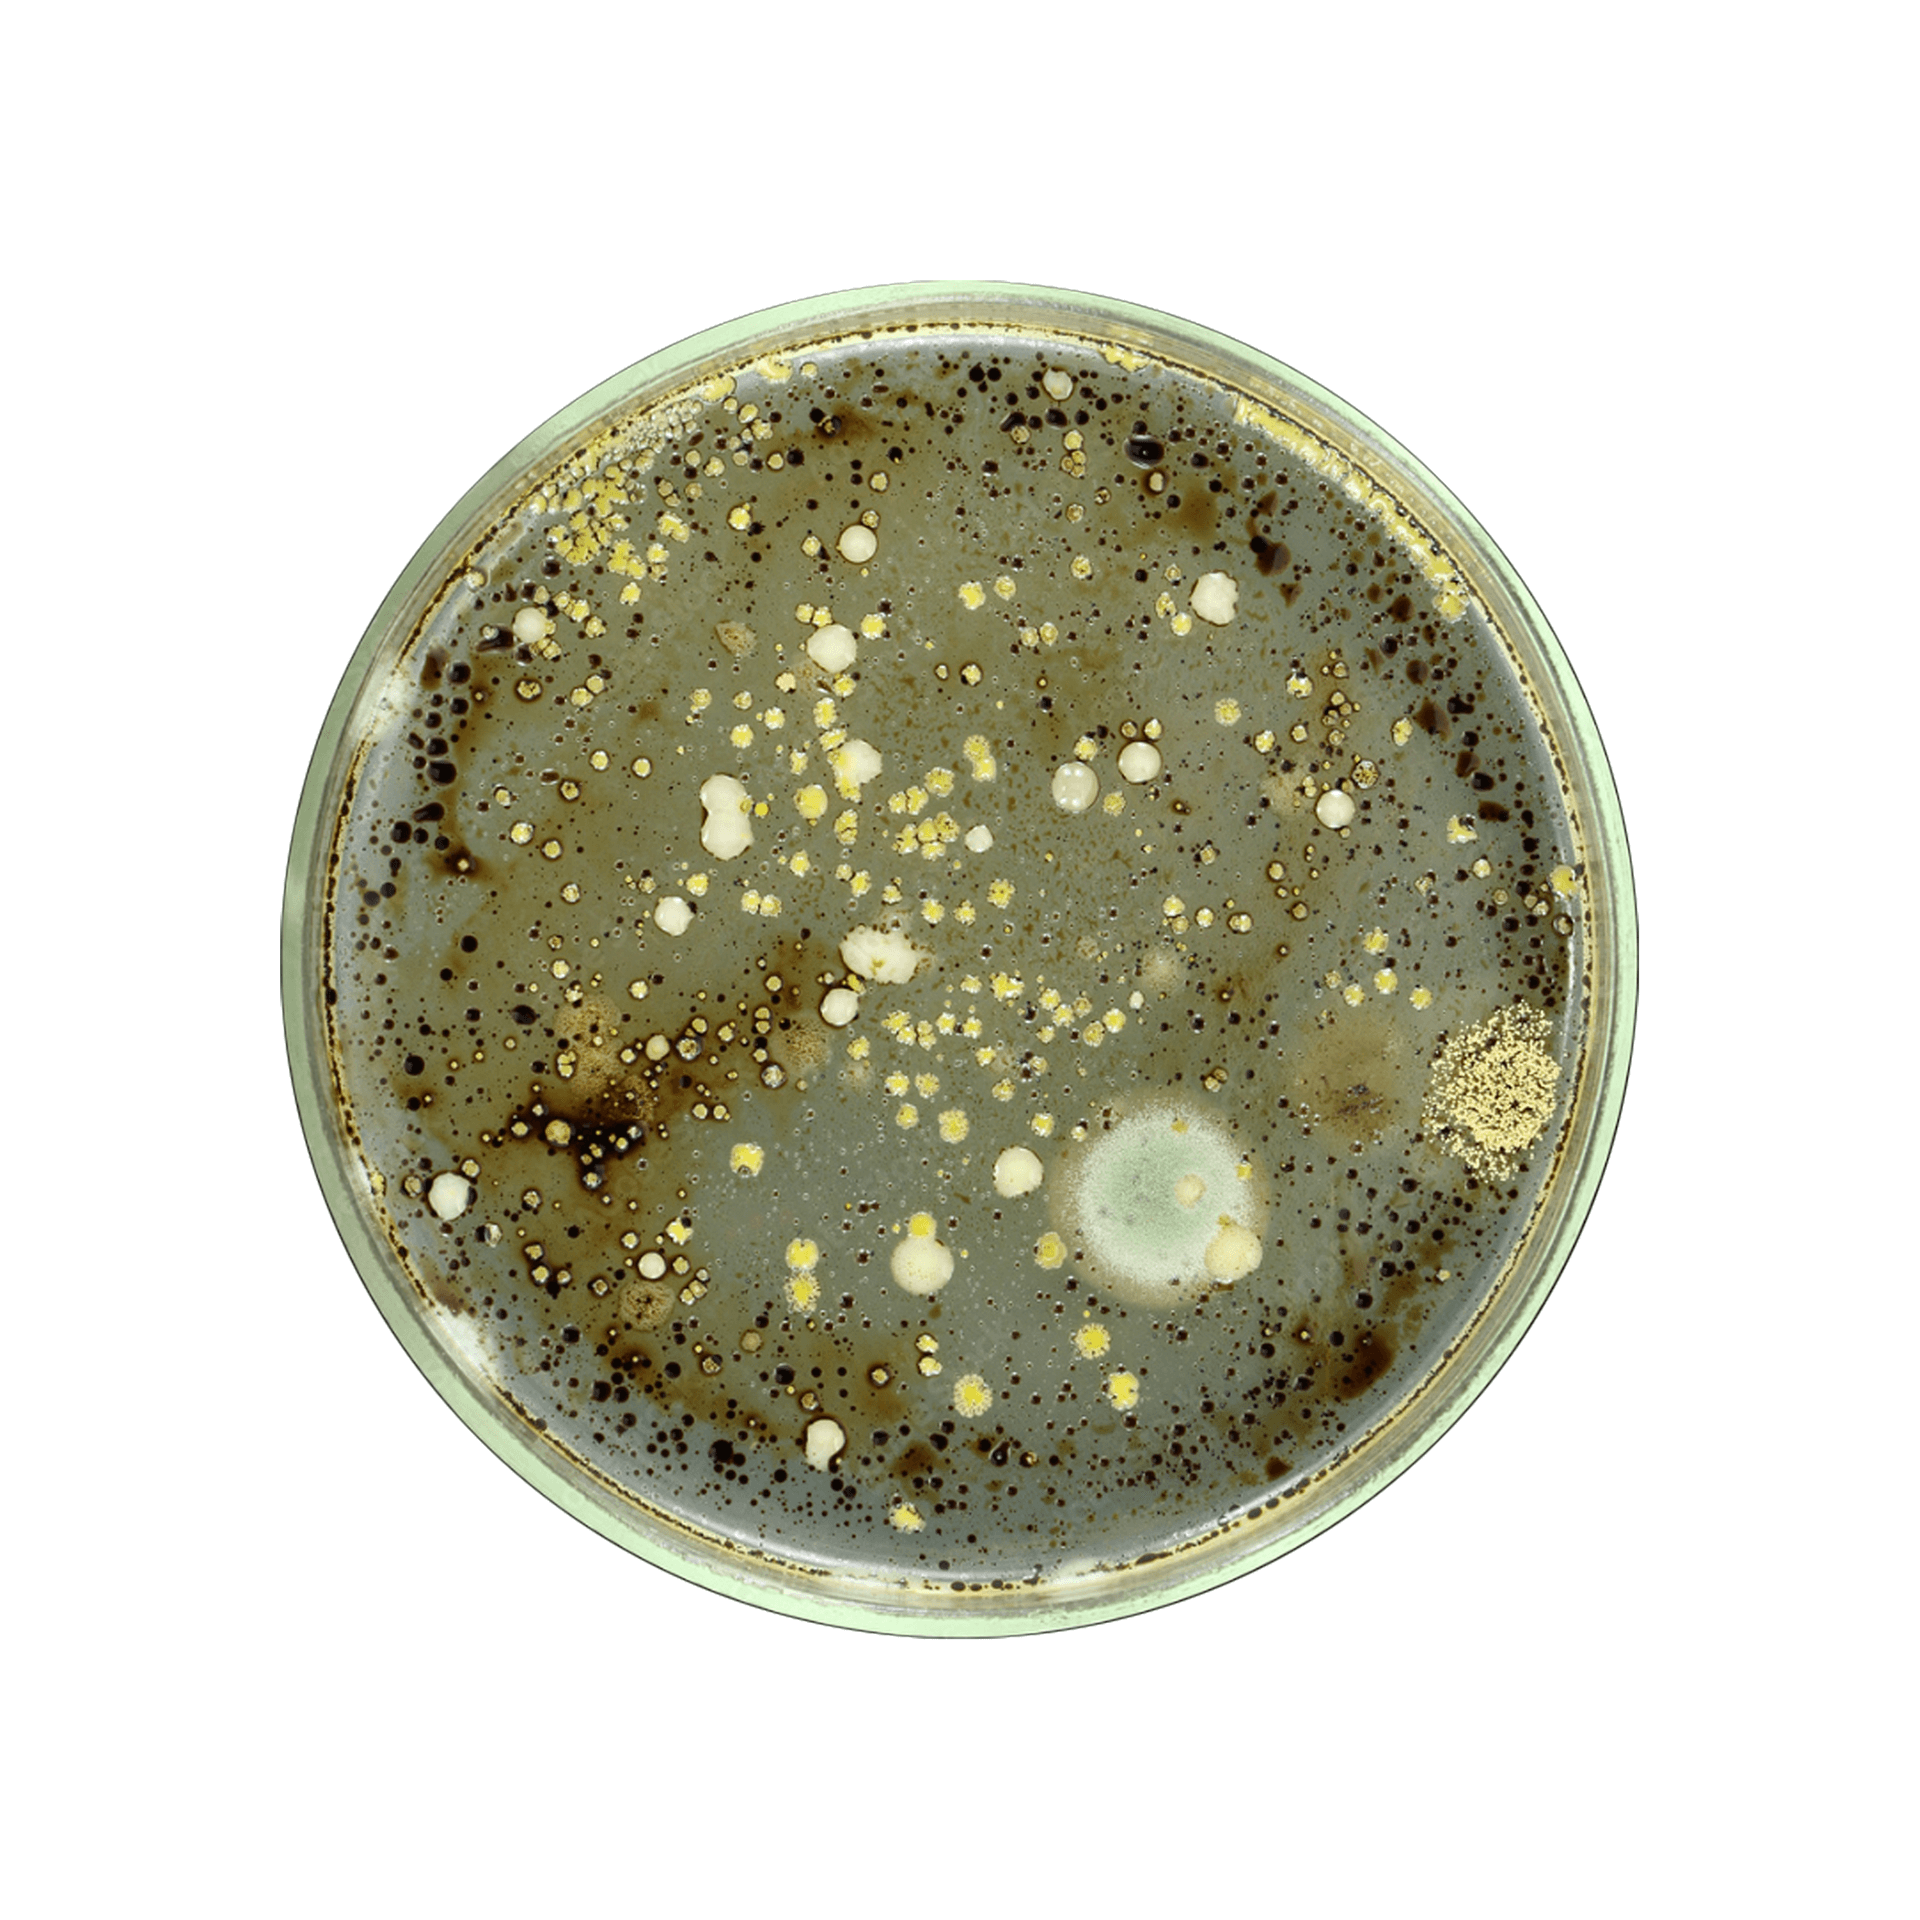

The air for pharmaceutical and medical uses must absolutely be held to the highest standards. The care and very lives of the most vulnerable depend on the quality and safety of the gases used in hospitals, such as nitrogen, oxygen, air, and carbon dioxide. Safety Lab Plus tests for the NFPA 99, USP, Grade N, ISO8573-1, and other standards used in hospital and pharmaceutical settings. Trust us to help you deliver optimum confidence and care.
For more info| Class | > 0.1 - ≤ 0.5 (μm) | > 0.5 - ≤ 1.0 (μm) | > 1.0 - ≤ 5.0 (μm) | Dew Point | Oil (mg/m3) | Microbial (CFU) |
| 0 | *User or Supplier | *User or Supplier | *User or Supplier | *User or Supplier | *User or Supplier | ---- |
| 1 | ≤ 20,000 | ≤ 400 | ≤ 10 | ≤ -70°C / -94°F | 0.01 | ---- |
| 2 | ≤ 400,000 | ≤ 6,000 | ≤ 100 | ≤ -40°C / -40°F | 0.1 | ---- |
| 3 | Not Specified | ≤ 90,000 | ≤ 1,000 | ≤ -20°C / -4°F | 1 | ---- |
| 4 | Not Specified | Not Specified | ≤ 10,000 | ≤ +3°C / +38°F | 5 | ---- |
| 5 | Not Specified | Not Specified | ≤ 100,000 | ≤ +7°C / +45°F | ---- | ---- |
| 6 | ---- | ---- | ---- | ≤ +10°C / +50°F | ---- | ---- |
*As specified by the equipment user or supplier